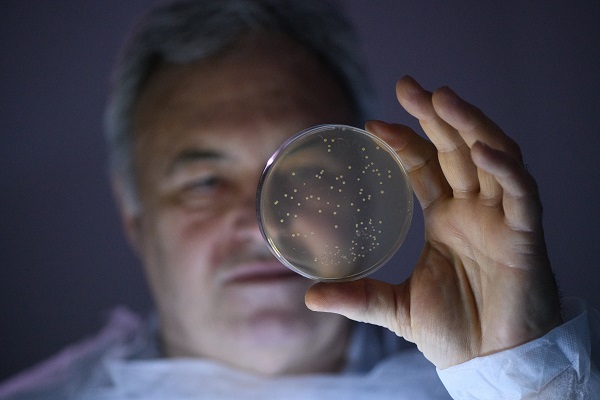

Спасен, за да спасява
Едно от най-прекрасните неща на този свят е човек да трансформира своето занимание в работа и да прави това, което му е на сърце. Иван Лесев от Габрово е постигнал това съвършенство, макар че има много необикновена пристрастеност - да обикаля света и да внедрява новаторски решения, които оказват помощ на хората да се оправят с сложни за медицината здравословни проблеми.
Компанията, която Лесев ръководи, „ Медбио “, не е огромна, само че резултатите, които реализира, са неизмерими с пари. Те стопират коликите на дребните бебенца! Успокояват майките, мъжете не помнят за подаграта, възрастните – за високото кръвно, изчезва дисбактериозата, което взема решение куп други здравословни провокации.
Може да се каже, че активността на Иван Лесев самоуверено попълня празноти в медицината с техники и артикули, които потвърдено работят, само че не съставляват интерес за бизнеса, защото не са задоволително печеливши. А може би и тъй като, спасявайки хората от хронични проблеми, те стопират абонамента си да одобряват медикаменти всеки ден.
„ Няма нещо, което да ми носи по-голямо задоволство от това - да ми каже някоя майка: „ Ти ми избави детето! “, споделя Иван Лесев, когато го питаме за какво е зарязал огромния бизнес, с цел да се занимава с тази активност. „ Бях в реанимация и там, до момента в който гледах тавана, осъзнах, че катафалката няма ремарке. Бидейки сред живота и гибелта, на човек му идват доста мисли в главата... “, споделя мъжът.

По сложния метод
Той открива своето предопределение доброзорно. Преди да се разболее, габровецът е един от най-заможните и авторитетни хора в града. Той е с две висши образования (инженерно и финанси) и аспирантура, само че има и вродена заложба да сбъдва концепциите си. Затова бизнесът му иде отръки. Мениджър е на компании в козметиката, машиностроенето, фотоволтаици, хотелиерство... „ Създал съм 15 разнообразни производства в най-различни области. По едно време в холдинг STS работeха 3000 души. Произвеждахме паста за зъби и изнасяхме за Русия по 11-12 млн. на месец “, спомня си Лесев.
Но цената на този триумф е доста висока: малко сън, доста цигари, непрестанен стрес. Резултатът – заболявания, които идват на вълни: високо кръвно, плеврален излив, перикарден излив... Година и половина по-късно той e в реанимация с цялостен сепсис.
„ Едва оцелях. От цялостен сепсис оживяват 1%. Аз съм от този 1 % “, споделя Иван. Когато го изписват, той не може да се възвърне: има високо кръвно налягане, имунитетът му е срутен, непрестанно го атакуват бактерии, има хронична венозна непълнота, разболява се доста постоянно, безусловно през месец... За да си помогне, стартира да чете здравна литература. Изоставя всичко друго, осъзнава, че повторно няма да има подобен шанс.

Прeпрочита учебници, научни публикации, гледа документални филми. Абонира се за библиотеката на Руската академия на науките, където намира доста скъпа информация. Но тя не му е задоволителна. Решава да се срещне персонално с хората, чиито каузи, отдадени на здравето, го впечатляват, и да тества върху себе си техните открития.
Тръгвайки по този път, Иван открива, че всички порти изненадващо се отварят с лекост пред него. Сякаш самото божество го води.
В Астрахан – в института по галактическа медицина
Първото място, което посещава, е Институтът по авиационна и галактическа медицина в Астрахан, Русия. Там проф. Иван Полунин е изобретил методика за лекуване на високо кръвно налягане.

В Тибет за детоксикацияСледващото странствуване в търсене на здраве е Тибет. Заедно с другари Иван отива в център за детоксикация при брачната половинка на австралиеца Даниел Рийд, създател на книгата „ Дао на прочистването “. Води ги изпълнителният шеф на фармацевтична компания, на който медицината не може да помогне да се излекува от розацея. „ Беше ходил под дърво и камък... а там единствено за две седмици се оправи! С нас беше и жена, която не можеше да има дете. На третия месец забременя! “
Жоао де Деус е един от най-великите биотерапевти на нашето време. Иван остава при него две седмици дружно с още 7 българи. Единият е с отлепена ретина на едното око и нищо не вижда с него. Жоао му предлага да го оперира. Асистентите му подават скалпел. „ Той го взе и пред всичките 1000 индивида в залата стартира нещо да стърже. 1-2 минути нещо правеше по окото и му сподели: „ Хайде, подготвен си “. Взе тампон с вода, постави го върху окото и му сподели да го махне след 24 часа. На другия ден в 14 ч. всички българи се събрахме, с цел да забележим какво ще стане. Той си махна превръзката и сподели: „ Хора, виждам си линиите на ръката!? “.
„ Имаше и една стюардеса с множествена склероза. Когато ние бяхме там, тя беше за втори или трети път и ни сподели, че като посочила на доктор фотография на главата, той є споделил, че това, което вижда, и нейното положение са две изцяло разнообразни неща. Той не можел да си го изясни. Жената сподели, че с тази диагноза и с тази фотография тя би трябвало да е на инвалидна количка. А тя тичаше “, споделя Иван.
В Бразилия той се научава да бъде с отворено схващане, да има вяра в чудеса. И да не се отхвърля в никакъв случай, когато става дума за здраве и човешки живот.„ Там видяхме чудеса, които в действителност не можеш да си ги обясниш... “, споделя мъжът и погледът му потъва някъде далеко в Бразилия, при магичния врач във вълшебното място с големи кристали.
В Новосибирск избавят микробиома
Проф. доктор Ашот Хачатрян е знаменит академик в новото и перспективно направление в медицината, което учи микробиома. Хачатрян е приключил Ереванския медицински институт, след което се реалокира в Новосибирск, където работи и до през днешния ден. Член е на три Академии на науките. В болничното заведение в Новосибирск е излекувал над 50 000 души, част от които оповестени за „ нелечимо заболели “.
Автор е на книгата „ Дисбактериозата - епидемията на XXI век “. Иван отива при него в Новосибирск, с цел да пречисти организма си от паразити и да се излекува от тежка дисбактериоза, която получава след масираното лекуване с антибиотици, което са му ползвали. Дисбактериоза значи загуба на потребни бактерии (най-често поради антибиотици, храни с консерванти и др.) и замяната им с нездравословни за организма. Това има доста тежки последствия: хронична отмалялост, запек, диария, стомашно-чревни проблеми, алергии, атопичен дерматит... Може да се прояви и като прочувствени и психологични разстройства, защото по думите на Лесев „ връзката дебело черво – мозък е най-важната в организма, а информацията, която обменят - 400 пъти повече от тази, която пътува от мозъка до другите елементи на тялото “.
Българинът бързо се сприятелява и с този професор. Договарят се той да идва на всеки 3 месеца в Кюстендил и да води оздравителни курсове на българи, руснаци и украинци. Ембаргото към Русия обаче поставя завършек на тези занимания, защото не разрешават на клиентите - държавни чиновници, да идват в България. След това политическо решение Лесев е заставен да продаде хотел „ Стримон “ в Кюстендил. Не съжалява. Предстоят му доста по-интересни и потребни за хората действия.

Да отглеждаш пробиотици„ Човек е човек единствено 10 %. Останалото са бактерии, вируси и микроорганизми, изяснява шефът на „ Медбио “. - Това, като се смеси, става геном, напълно друг от нашата клетка “, напомня Иван Лесев.
Впрочем здравословните проблеми поради увреждане на микробиома стартират още през първите дни след раждането на детето. Ако майката роди със секцио, тя не може да съобщи потребни пробиотици от родовите пътища на своята рожба. Същото се отнася и за майки, които са пили антибиотици, или са консумирали храни с консерванти, което унищожава микрофлората им. Затова, когато се родят, доста бебета имат колики и плачат непрекъснато. Дете, на което майката е имала естествена микрофлора, няма колики.
Иван Лесев научава извънредно доста за пробиотиците от проф. Ашот Хачатрян и става производител за България. Когато на децата се дадат пробиотици „ Нарине “ на „ Медбио “, те се успокояват още на втория-третия банкет. Трябва единствено да се внимава с приспособените млека, защото в някои от тях има консерванти и те убиват положителните бактерии, предизвестява Лесев. Подобряването на микрофлората взема решение и голям брой други проблеми. Затова предприемачът предлага, в случай че човек има някакви неразположения, на първо време да оправи микросвета в себе си.
Но нали България е родината на най-хубавите бактерии лактобацилус булгарикус? Оказва се, че с изключение на нея има и друга млечно кисела бактерия, която е не по-малко потребна. През 1964 година в Арменската академия на науките проф. Левон Ерзинкян я открива и с нея избавя внучето си, което е на 4-5 години и е с тежка дисбактериоза поради антибиотици. Кръщава я „ Нарине “, на внучката си. Тази бактерия има способността да се засели в дебелото ни черво. Затова тя участва в част от пробиотиците, които Иван Лесев стартира да създава. Той даже записва комерсиална марка „ Нарине “ за Европа.
За да се заселят положителните бактерии, „ Медбио “ ги продават живи, в течна форма, те се транспортират в хладилен пакет, а дружно с тях се приема и „ храната “ им. След като създадат колония, в случай че внимаваме да не ги унищожим, те стават наши правилни помощници за цялостен живот. А това значи, че те няма да позволен в дебелото черво неприятни бактерии, даже резистентните.
Това не може да е правилно
Спасение при хрема и бактериална вагиноза
Едни от най-новите посоки в активността на бизнесмена са необикновените приложения на живи пробиотични бактерии – в носа и във влагалището.
Запушеният нос и/или хремата най-често са резултат от инфекции, породени от патогенни и условно патогенни микроорганизми, изяснява ни Иван Лесев. От носа бактериите и гъбичките се популяризират в синусите, устната празнина и ушите. Създаването на местна колония от живи потребни бактерии - антагонисти на патогенните микроорганизми, взема решение казуса. „ Заселваме в носа подобаващите живи бактерии с пробиотични капки за нос и ги оставяме да унищожават постъпващите посредством въздуха патогенни микроорганизми “, приказва разпалено Лесев.

Неговият екип е намерил решение и за упоритата бактериалната вагиноза, която елементарно става хронична и тормози доста дами. Тя се лекува мъчно, защото микрофлората на влагалището не се възвръща от единствено себе си, а е нужна външна помощ. Живите ацидофилни бактерии възвръщат вагиналната микрофлора и трайно отстраняват бактериалната вагиноза.
Когато пътят те открие
Освен с продуктите си, Иван оказва помощ на хората със познание. На уеб страницата на „ Медбио “ има публикации, видеа, филми и мнения на лекари за новости в медицината, с цел да са хората образовани и знаещи.
За контакт и повече информация:
www.medbio-bg.eu
www.medbio.life
087 935 3677
Материалът е оповестен в Списание 8, бр. 4/2022 г.
Компанията, която Лесев ръководи, „ Медбио “, не е огромна, само че резултатите, които реализира, са неизмерими с пари. Те стопират коликите на дребните бебенца! Успокояват майките, мъжете не помнят за подаграта, възрастните – за високото кръвно, изчезва дисбактериозата, което взема решение куп други здравословни провокации.
Може да се каже, че активността на Иван Лесев самоуверено попълня празноти в медицината с техники и артикули, които потвърдено работят, само че не съставляват интерес за бизнеса, защото не са задоволително печеливши. А може би и тъй като, спасявайки хората от хронични проблеми, те стопират абонамента си да одобряват медикаменти всеки ден.
„ Няма нещо, което да ми носи по-голямо задоволство от това - да ми каже някоя майка: „ Ти ми избави детето! “, споделя Иван Лесев, когато го питаме за какво е зарязал огромния бизнес, с цел да се занимава с тази активност. „ Бях в реанимация и там, до момента в който гледах тавана, осъзнах, че катафалката няма ремарке. Бидейки сред живота и гибелта, на човек му идват доста мисли в главата... “, споделя мъжът.

По сложния метод
Той открива своето предопределение доброзорно. Преди да се разболее, габровецът е един от най-заможните и авторитетни хора в града. Той е с две висши образования (инженерно и финанси) и аспирантура, само че има и вродена заложба да сбъдва концепциите си. Затова бизнесът му иде отръки. Мениджър е на компании в козметиката, машиностроенето, фотоволтаици, хотелиерство... „ Създал съм 15 разнообразни производства в най-различни области. По едно време в холдинг STS работeха 3000 души. Произвеждахме паста за зъби и изнасяхме за Русия по 11-12 млн. на месец “, спомня си Лесев.
Но цената на този триумф е доста висока: малко сън, доста цигари, непрестанен стрес. Резултатът – заболявания, които идват на вълни: високо кръвно, плеврален излив, перикарден излив... Година и половина по-късно той e в реанимация с цялостен сепсис.
„ Едва оцелях. От цялостен сепсис оживяват 1%. Аз съм от този 1 % “, споделя Иван. Когато го изписват, той не може да се възвърне: има високо кръвно налягане, имунитетът му е срутен, непрестанно го атакуват бактерии, има хронична венозна непълнота, разболява се доста постоянно, безусловно през месец... За да си помогне, стартира да чете здравна литература. Изоставя всичко друго, осъзнава, че повторно няма да има подобен шанс.
Прeпрочита учебници, научни публикации, гледа документални филми. Абонира се за библиотеката на Руската академия на науките, където намира доста скъпа информация. Но тя не му е задоволителна. Решава да се срещне персонално с хората, чиито каузи, отдадени на здравето, го впечатляват, и да тества върху себе си техните открития.
Тръгвайки по този път, Иван открива, че всички порти изненадващо се отварят с лекост пред него. Сякаш самото божество го води.
В Астрахан – в института по галактическа медицина
Първото място, което посещава, е Институтът по авиационна и галактическа медицина в Астрахан, Русия. Там проф. Иван Полунин е изобретил методика за лекуване на високо кръвно налягане.
„ Бях учуден. Как по този начин? Нали есенциална хипертония значи безпричинна? Как да излекуваш нещо, което няма причина? Но се оказа, че може. Професорът потвърждава, че посредством дишане могат да се оправят доста проблеми, и за 3-4 месеца високото кръвно изчезва “, споделя Иван Лесев.Той бързо се сприятелява със 72-годишния професор, който остава учуден от познанията на българина, препрочел няколко пъти трудовете му, преди да се срещне с учения. Иван стартира да употребява уреда за дишане, изобретен от Полунин, и кръвното му се възстановява. А Лесев взема решение да създава в България тренажора на проф. Полунин, с цел да помогне и на други българи с хипертония.

В Тибет за детоксикацияСледващото странствуване в търсене на здраве е Тибет. Заедно с другари Иван отива в център за детоксикация при брачната половинка на австралиеца Даниел Рийд, създател на книгата „ Дао на прочистването “. Води ги изпълнителният шеф на фармацевтична компания, на който медицината не може да помогне да се излекува от розацея. „ Беше ходил под дърво и камък... а там единствено за две седмици се оправи! С нас беше и жена, която не можеше да има дете. На третия месец забременя! “
Коя е тайната на правилнoто филтриране – апетит ли?, питаме Иван и оставаме изумени от отговора. „ Не, това е най-неефективният метод за детоксикация. Токсините са водоразтворими и когато минат през дебелото черво, то връща водата назад и дружно с нея и разтворените токсини, които се въртят в организма. Затова би трябвало да се постави капан (най-често хуск – семената на живовляк), който да улови токсините. Ние произвеждаме два типа детоксиканти и след всяко пречистване има „ капан “. Ето това съм го научил в Тибет. По този метод успеваемостта на детоксикацията става 80-90 % “.В Бразилия при Жоао
Жоао де Деус е един от най-великите биотерапевти на нашето време. Иван остава при него две седмици дружно с още 7 българи. Единият е с отлепена ретина на едното око и нищо не вижда с него. Жоао му предлага да го оперира. Асистентите му подават скалпел. „ Той го взе и пред всичките 1000 индивида в залата стартира нещо да стърже. 1-2 минути нещо правеше по окото и му сподели: „ Хайде, подготвен си “. Взе тампон с вода, постави го върху окото и му сподели да го махне след 24 часа. На другия ден в 14 ч. всички българи се събрахме, с цел да забележим какво ще стане. Той си махна превръзката и сподели: „ Хора, виждам си линиите на ръката!? “.
„ Имаше и една стюардеса с множествена склероза. Когато ние бяхме там, тя беше за втори или трети път и ни сподели, че като посочила на доктор фотография на главата, той є споделил, че това, което вижда, и нейното положение са две изцяло разнообразни неща. Той не можел да си го изясни. Жената сподели, че с тази диагноза и с тази фотография тя би трябвало да е на инвалидна количка. А тя тичаше “, споделя Иван.
В Бразилия той се научава да бъде с отворено схващане, да има вяра в чудеса. И да не се отхвърля в никакъв случай, когато става дума за здраве и човешки живот.„ Там видяхме чудеса, които в действителност не можеш да си ги обясниш... “, споделя мъжът и погледът му потъва някъде далеко в Бразилия, при магичния врач във вълшебното място с големи кристали.
В Новосибирск избавят микробиома
Проф. доктор Ашот Хачатрян е знаменит академик в новото и перспективно направление в медицината, което учи микробиома. Хачатрян е приключил Ереванския медицински институт, след което се реалокира в Новосибирск, където работи и до през днешния ден. Член е на три Академии на науките. В болничното заведение в Новосибирск е излекувал над 50 000 души, част от които оповестени за „ нелечимо заболели “.
Автор е на книгата „ Дисбактериозата - епидемията на XXI век “. Иван отива при него в Новосибирск, с цел да пречисти организма си от паразити и да се излекува от тежка дисбактериоза, която получава след масираното лекуване с антибиотици, което са му ползвали. Дисбактериоза значи загуба на потребни бактерии (най-често поради антибиотици, храни с консерванти и др.) и замяната им с нездравословни за организма. Това има доста тежки последствия: хронична отмалялост, запек, диария, стомашно-чревни проблеми, алергии, атопичен дерматит... Може да се прояви и като прочувствени и психологични разстройства, защото по думите на Лесев „ връзката дебело черво – мозък е най-важната в организма, а информацията, която обменят - 400 пъти повече от тази, която пътува от мозъка до другите елементи на тялото “.
Българинът бързо се сприятелява и с този професор. Договарят се той да идва на всеки 3 месеца в Кюстендил и да води оздравителни курсове на българи, руснаци и украинци. Ембаргото към Русия обаче поставя завършек на тези занимания, защото не разрешават на клиентите - държавни чиновници, да идват в България. След това политическо решение Лесев е заставен да продаде хотел „ Стримон “ в Кюстендил. Не съжалява. Предстоят му доста по-интересни и потребни за хората действия.

Да отглеждаш пробиотици„ Човек е човек единствено 10 %. Останалото са бактерии, вируси и микроорганизми, изяснява шефът на „ Медбио “. - Това, като се смеси, става геном, напълно друг от нашата клетка “, напомня Иван Лесев.
Впрочем здравословните проблеми поради увреждане на микробиома стартират още през първите дни след раждането на детето. Ако майката роди със секцио, тя не може да съобщи потребни пробиотици от родовите пътища на своята рожба. Същото се отнася и за майки, които са пили антибиотици, или са консумирали храни с консерванти, което унищожава микрофлората им. Затова, когато се родят, доста бебета имат колики и плачат непрекъснато. Дете, на което майката е имала естествена микрофлора, няма колики.
Иван Лесев научава извънредно доста за пробиотиците от проф. Ашот Хачатрян и става производител за България. Когато на децата се дадат пробиотици „ Нарине “ на „ Медбио “, те се успокояват още на втория-третия банкет. Трябва единствено да се внимава с приспособените млека, защото в някои от тях има консерванти и те убиват положителните бактерии, предизвестява Лесев. Подобряването на микрофлората взема решение и голям брой други проблеми. Затова предприемачът предлага, в случай че човек има някакви неразположения, на първо време да оправи микросвета в себе си.
Но нали България е родината на най-хубавите бактерии лактобацилус булгарикус? Оказва се, че с изключение на нея има и друга млечно кисела бактерия, която е не по-малко потребна. През 1964 година в Арменската академия на науките проф. Левон Ерзинкян я открива и с нея избавя внучето си, което е на 4-5 години и е с тежка дисбактериоза поради антибиотици. Кръщава я „ Нарине “, на внучката си. Тази бактерия има способността да се засели в дебелото ни черво. Затова тя участва в част от пробиотиците, които Иван Лесев стартира да създава. Той даже записва комерсиална марка „ Нарине “ за Европа.
За да се заселят положителните бактерии, „ Медбио “ ги продават живи, в течна форма, те се транспортират в хладилен пакет, а дружно с тях се приема и „ храната “ им. След като създадат колония, в случай че внимаваме да не ги унищожим, те стават наши правилни помощници за цялостен живот. А това значи, че те няма да позволен в дебелото черво неприятни бактерии, даже резистентните.
Това не може да е правилно
„ Науката при мен е доста мощно застъпена. Аз нищо не върша, в случай че не е потвърдено и тествано. Понякога класическата медицина споделя: Това не може да е правилно. Но когато имаш проучвания, изследвания и доказателства, това не би трябвало да те стопира. “И габровецът фактически не стопира – пътува, търси нови ефикасни способи за битка с разнообразни заболявания и се пробва да ги вкара в родината си. Бил е в Унгария, в института „ Макс Герсон “. Герсон е доктор, разрешил си още при започване на ХХ век да пробва да лекува онкологични болести посредством хранителен режим, основан главно на вегетарианска храна и сокове.
Спасение при хрема и бактериална вагиноза
Едни от най-новите посоки в активността на бизнесмена са необикновените приложения на живи пробиотични бактерии – в носа и във влагалището.
Запушеният нос и/или хремата най-често са резултат от инфекции, породени от патогенни и условно патогенни микроорганизми, изяснява ни Иван Лесев. От носа бактериите и гъбичките се популяризират в синусите, устната празнина и ушите. Създаването на местна колония от живи потребни бактерии - антагонисти на патогенните микроорганизми, взема решение казуса. „ Заселваме в носа подобаващите живи бактерии с пробиотични капки за нос и ги оставяме да унищожават постъпващите посредством въздуха патогенни микроорганизми “, приказва разпалено Лесев.

Неговият екип е намерил решение и за упоритата бактериалната вагиноза, която елементарно става хронична и тормози доста дами. Тя се лекува мъчно, защото микрофлората на влагалището не се възвръща от единствено себе си, а е нужна външна помощ. Живите ацидофилни бактерии възвръщат вагиналната микрофлора и трайно отстраняват бактериалната вагиноза.
Когато пътят те открие
Освен с продуктите си, Иван оказва помощ на хората със познание. На уеб страницата на „ Медбио “ има публикации, видеа, филми и мнения на лекари за новости в медицината, с цел да са хората образовани и знаещи.
„ Да оказвам помощ на хората, ми носи голямо задоволство. Тъй като цялостен живот съм създавал нови неща, в кръвта ми е да осъществявам нововъведения. Научаваш нещо, осъзнаваш, че можеш да го направиш, и го правиш “ – споделя Иван за себе си. Той е уверен, че следва пътя си, предначертан от Бог, Създателя, Твореца, Природата – без значение по какъв начин ще го назовем.
За контакт и повече информация:
www.medbio-bg.eu
www.medbio.life
087 935 3677
Материалът е оповестен в Списание 8, бр. 4/2022 г.
Източник: spisanie8.bg

КОМЕНТАРИ





